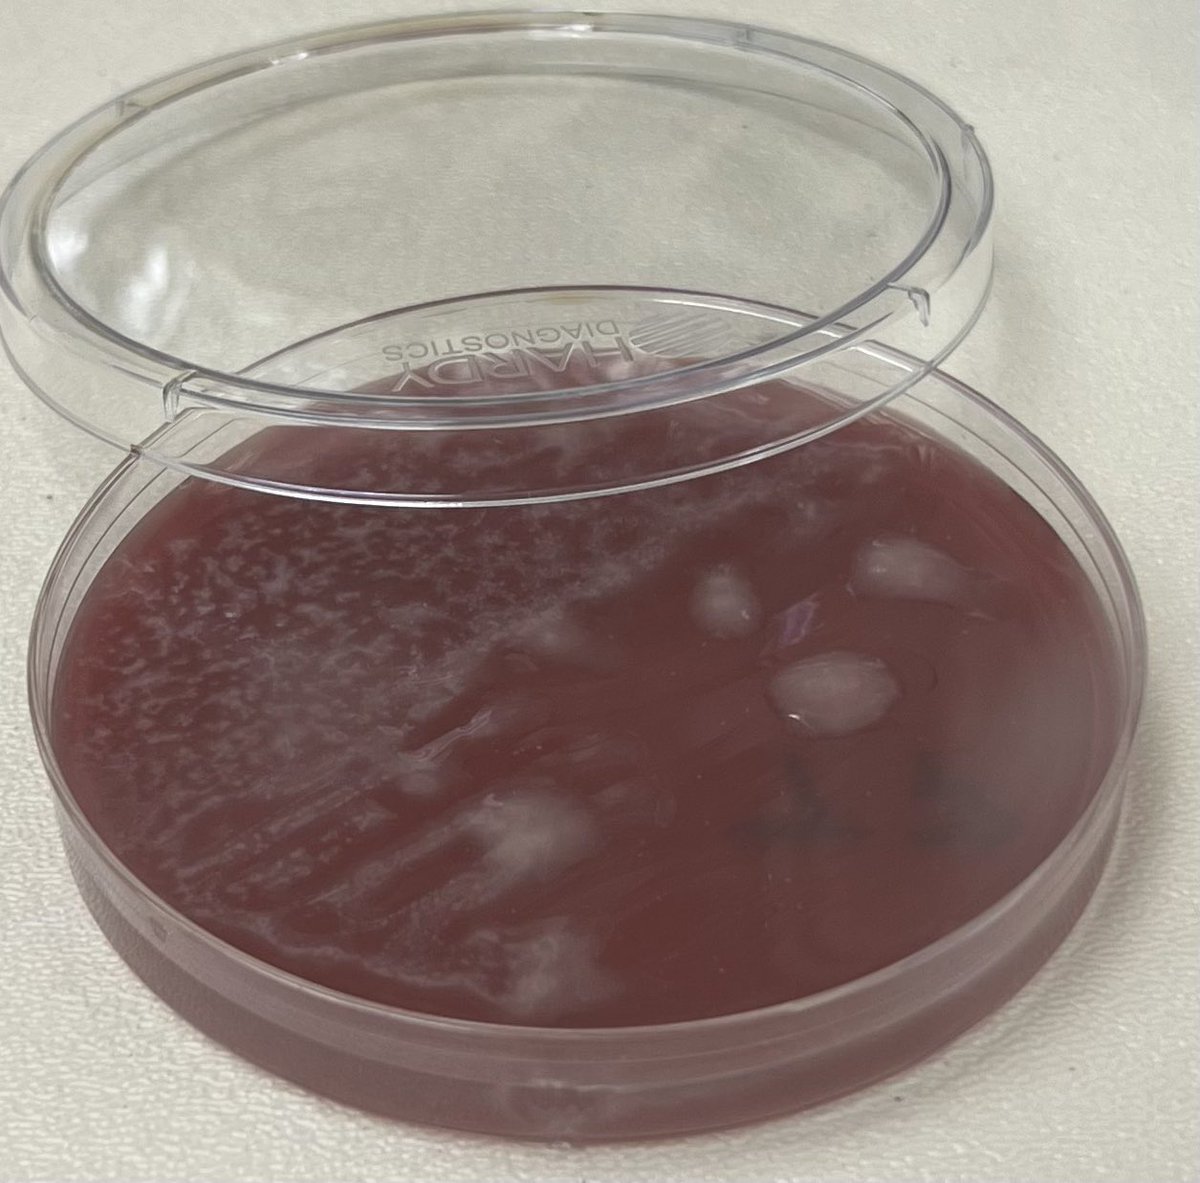
Sam Miller, Ph.D. tweet media
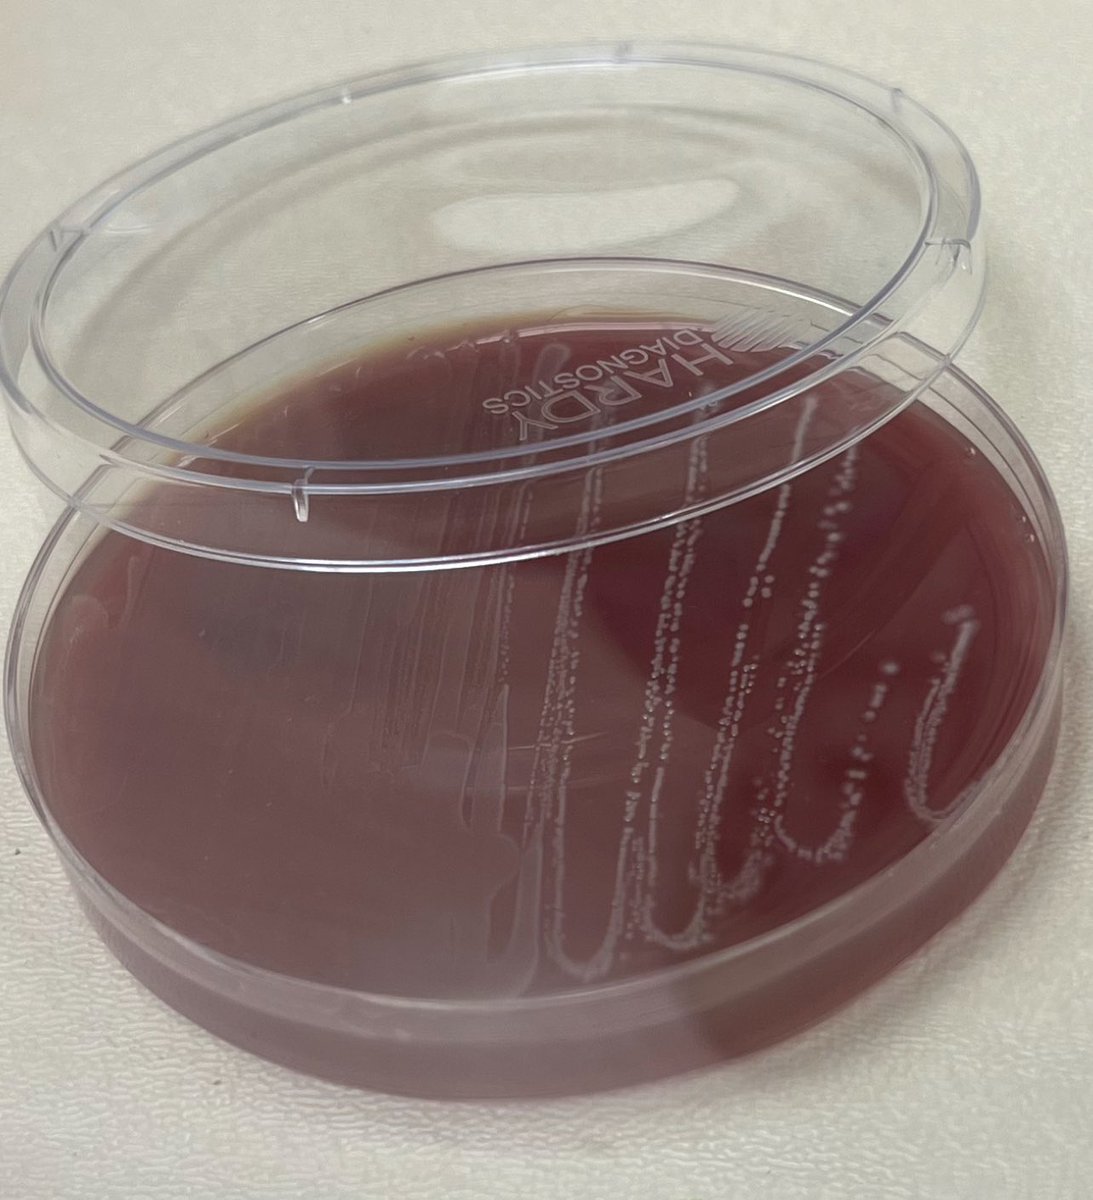
Sam Miller, Ph.D. tweet media

🔬 Exploring the Hidden World of Gut Bacteria with @MicrobeMiller In this episode, we sit down with Dr. Samuel Miller, a leading scientist at Oklahoma State University, to dive deep into the fascinating world of culturomics and the microbial universe. 🌱 🎶tinyurl.com/yjpeku6p Dr. Miller’s research is uncovering the mysteries of anaerobic bacteria and their crucial role in human health. From anaerobic vs aerobic bacteria to groundbreaking discoveries on uncultivated microbes, get ready for an inside look at the cutting-edge work that’s reshaping our understanding of gut health. 🧬 🎧 What you'll learn: 🦠 The major differences between anaerobic & aerobic bacteria 🌍 What happens when anaerobes are exposed to oxygen 💡 How bacteria are helping us improve health Follow Dr. Miller’s groundbreaking research on LinkedIn: linkedin.com/in/MicrobeMill… 🎧 Listen now on Apple Podcasts: apple.co/30PvU9C . . . #Microbiome #Culturomics #AnaerobicMicrobiology #GutHealth #MicrobialResearch #Phage #HealthScience #Bacteria #FindingGeniusPodcast #OSU #Biodiversity #Microbiomics #MicrobialWorld #16SrRNA #HealthInnovation